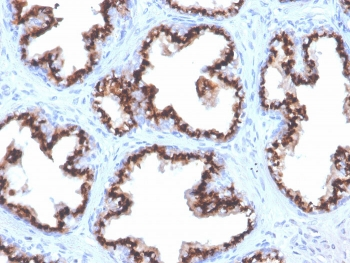
Recombinant Prostein Antibody / SLC45A3

You have no items in your shopping cart.
Search results for: 'antibody'
- Recombinant Prostein Antibody / SLC45A3 [orb699668]
IHC-P
Human
Rabbit
Recombinant
Unconjugated
100 μg, 20 μg - Recombinant E-Cadherin Antibody / CDH1 [orb699729]
IHC-P
Human
Rabbit
Recombinant
Unconjugated
100 μg, 20 μg - Recombinant Catenin beta Antibody [orb699582]
ELISA, FACS, IHC-P
Human
Mouse
Recombinant
Unconjugated
100 μg, 20 μg - Pan Cytokeratin Antibody Cocktail (Acidic + Basic) [orb1825076]
FACS, IF, IHC-P, WB
Human
Rabbit
Recombinant
Unconjugated
100 μg - Pan Cytokeratin Antibody Cocktail (Acidic + Basic) [orb1825077]
FACS, IF, IHC-P, WB
Human
Rabbit
Recombinant
Unconjugated
100 μg, 20 μg IHC-P
Human
Rabbit
Recombinant
Unconjugated
100 μg